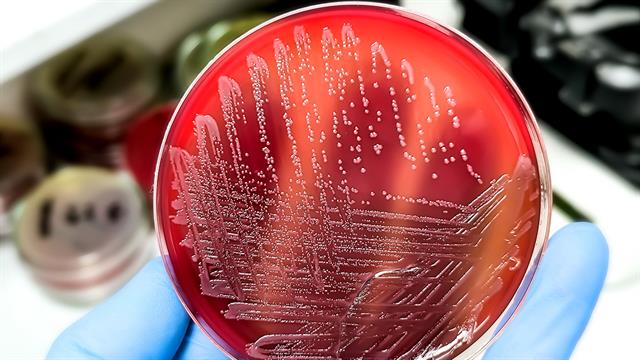
ΕΟΦ: Συμπλήρωμα διατροφής συνδέεται με επιδημία σαλμονέλωσης

Πιθανή και στην Ελλάδα είναι η διακίνηση συμπληρώματος διατροφής, το οποίο συνδέεται με επιδημία σαλμονέλωσης στις ΗΠΑ.
Τον κώδωνα του κινδύνου κρούουν οι υπεύθυνοι του Εθνικού Οργανισμού Φαρμάκων (ΕΟΦ). Σε σημερινή ανακοίνωση του ΕΟΦ αναφέρονται τα ακόλουθα:
Ο ΕΟΦ προειδοποιεί ότι το συμπλήρωμα διατροφής Moringa Powder της εταιρείας Rosabella το οποίο κυκλοφορεί στις ΗΠΑ συνδέεται για την επιδημία σαλμονέλωσης που σχετίζεται με την κατανάλωση του πιο πάνω αναφερόμενου συμπληρώματος διατροφής.
Το προϊόν πωλείται μέσω Διαδικτύου, συμπεριλαμβανομένων όλων των πλατφορμών πώλησης προϊόντων, επομένως είναι πιθανή η διακίνησή του και στην Ελλάδα.
Κατόπιν όλων των ανωτέρω ο ΕΟΦ καλεί τους καταναλωτές να μην προβούν σε προμήθεια και χρήση του συγκεκριμένου προϊόντος οποιασδήποτε παρτίδας και σε περίπτωση που έρθει στην κατοχή τους τα προϊόντα, να μην τα χρησιμοποιήσουν και να ενημερώσουν άμεσα τον ΕΟΦ.
Αυτά τα προϊόντα ενδέχεται να προωθούνται στην Ελλάδα μέσω Διαδικτύου.
Επισημαίνεται ότι η αγορά προϊόντων αρμοδιότητας ΕΟΦ από μη αξιόπιστες πηγές, όπως είναι το Διαδίκτυο, μπορεί να θέσει σε κίνδυνο την υγεία του καταναλωτή.
Η πιο πάνω ειδοποίηση γίνεται ύστερα από ενημέρωση του ΕΟΦ από τον Ενιαίο Φορέα Ελέγχου Τροφίμων (ΕΦΕΤ).
Προσθέστε το iatronet.gr στο DiscoverΕιδήσεις υγείας σήμερα
Πέρα δώθε
Ρεκόρ θερμοκρασίας στη Βρετανία τον Ιούνιο
Τριμάρισμα βλεφαρίδων: Άλλο ένα ανεκδιήγητο trend του TikTok
Γρίπη και σαλμονέλωση κάνουν θραύση στην Ελλάδα - Αύξηση 46,9% στα λοιμώδη νοσήματα [πίνακας]
Γρίπη και σαλμονέλωση κάνουν θραύση στην Ελλάδα - Αύξηση 46,9% στα λοιμώδη νοσήματα [πίνακας] Ανάκληση προϊόντος “Σουβλάκι κοτόπουλο με πιπεριά”
Ανάκληση προϊόντος “Σουβλάκι κοτόπουλο με πιπεριά”  ECDC: Κρούσματα σαλμονέλλωσης από ντομάτες σε 16 ευρωπαϊκές χώρες
ECDC: Κρούσματα σαλμονέλλωσης από ντομάτες σε 16 ευρωπαϊκές χώρες Ανακαλούνται φτερούγες κοτόπουλου από τον Ε.Φ.Ε.Τ.
Ανακαλούνται φτερούγες κοτόπουλου από τον Ε.Φ.Ε.Τ. Θ. Ψαλτοπούλου: Τι είναι η σαλμονέλα που εντοπίστηκε σε δίκτυο ύδρευσης στη Μαγνησία
Θ. Ψαλτοπούλου: Τι είναι η σαλμονέλα που εντοπίστηκε σε δίκτυο ύδρευσης στη Μαγνησία ECDC: Κρούσματα σαλμονέλλωσης σε 9 ευρωπαϊκές χώρες - Φρέσκες ντομάτες η πηγή;
ECDC: Κρούσματα σαλμονέλλωσης σε 9 ευρωπαϊκές χώρες - Φρέσκες ντομάτες η πηγή; Τριμάρισμα βλεφαρίδων: Άλλο ένα ανεκδιήγητο trend του TikTok
Τριμάρισμα βλεφαρίδων: Άλλο ένα ανεκδιήγητο trend του TikTok Καροτιναιμία: Τι είναι και μπορεί να μας κάνει κακό;
Καροτιναιμία: Τι είναι και μπορεί να μας κάνει κακό; 5λεπτα διαλείμματα για περπάτημα ενισχύουν τη διάθεση και μειώνουν την κόπωση
5λεπτα διαλείμματα για περπάτημα ενισχύουν τη διάθεση και μειώνουν την κόπωση Χαμηλή πίεση και Alzheimer: Τι αποκαλύπτει νέα μελέτη
Χαμηλή πίεση και Alzheimer: Τι αποκαλύπτει νέα μελέτη Με ποιες τροφές να συνδυάζω ρύζι, πατάτες και ζυμαρικά για να μην αυξάνεται απότομα το σάκχαρο
Με ποιες τροφές να συνδυάζω ρύζι, πατάτες και ζυμαρικά για να μην αυξάνεται απότομα το σάκχαρο Ρύζι, πατάτες και ζυμαρικά: Ποιο είναι χειρότερο για το σάκχαρο;
Ρύζι, πατάτες και ζυμαρικά: Ποιο είναι χειρότερο για το σάκχαρο; Pharmathen: Βαθιά κρίση και μηδενισμός αποτίμησης από funds της Partners
Pharmathen: Βαθιά κρίση και μηδενισμός αποτίμησης από funds της Partners ΕΟΠΥΥ: Στο 1,1 δισ. ευρώ έκλεισαν clawback - rebate φαρμάκων το 2025 - Επίσημος απολογισμός
ΕΟΠΥΥ: Στο 1,1 δισ. ευρώ έκλεισαν clawback - rebate φαρμάκων το 2025 - Επίσημος απολογισμός Απ. Παπαλάκης: Ραγδαία αύξηση περιστατικών καρκίνου της ουροδόχου κύστης
Απ. Παπαλάκης: Ραγδαία αύξηση περιστατικών καρκίνου της ουροδόχου κύστης Συγκλονισμένοι οι υγειονομικοί από τον θάνατο 36χρονης γιατρού στη Μυτιλήνη
Συγκλονισμένοι οι υγειονομικοί από τον θάνατο 36χρονης γιατρού στη Μυτιλήνη Novo Nordisk Ελλάδος: Τιμήθηκε με το ‘’Σήμα Διαφορετικότητας’’ 2026 από το Υπουργείο Κοινωνικής Συνοχής & Οικογένειας
Novo Nordisk Ελλάδος: Τιμήθηκε με το ‘’Σήμα Διαφορετικότητας’’ 2026 από το Υπουργείο Κοινωνικής Συνοχής & Οικογένειας Καρπούζι: Ποια είναι τα οφέλη του στην υγεία
Καρπούζι: Ποια είναι τα οφέλη του στην υγεία